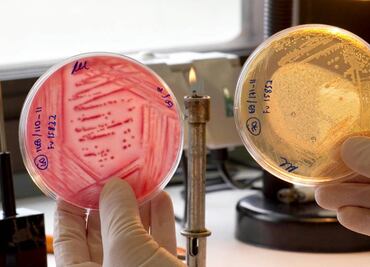
Bacteria E.coli puede causar infecciones urinarias: estudio

Las cepas extranjeras de la bacteria estomacal nociva "Helicobacter pylori" se mezclaron y reemplazaron a las cepas locales, revela un estudio reciente

Las cepas extranjeras de la bacteria estomacal nociva "Helicobacter pylori" se mezclaron y reemplazaron a las cepas locales, revela un estudio reciente

Durante un beso de 10 segundos se transmiten unas 80 millones de bacterias

Se estima que 600 millones de personas en el mundo son obesas y 400 millones sufren de diabetes

Estas especies exitosas en la naturaleza suelen resistirse a ser domesticadas y estudiadas

Así lo plantea un trabajo de opinión e investigación realizado por la estudiante Esperanza Sañudo en el Instituto Nacional de Ciencias Médicas y Nutrición “Salvador Zubirán”.

Un experimentó demostró como las bacterias se adaptan y logran sobrevivir

Pese a ser comunes, estos microorganismos pueden llegar a cualquier superficie y contaminar alimentos o utensilios
Pueden viajar a través de la uretra hasta la vejiga y causar "dolorosas infecciones"

Las bacterias son del mismo tipo que las que hay en bayetas y esponjas de la cocina

Permitirá a la industria alimentaria enriquecer sus productos con microorganismos benéficos